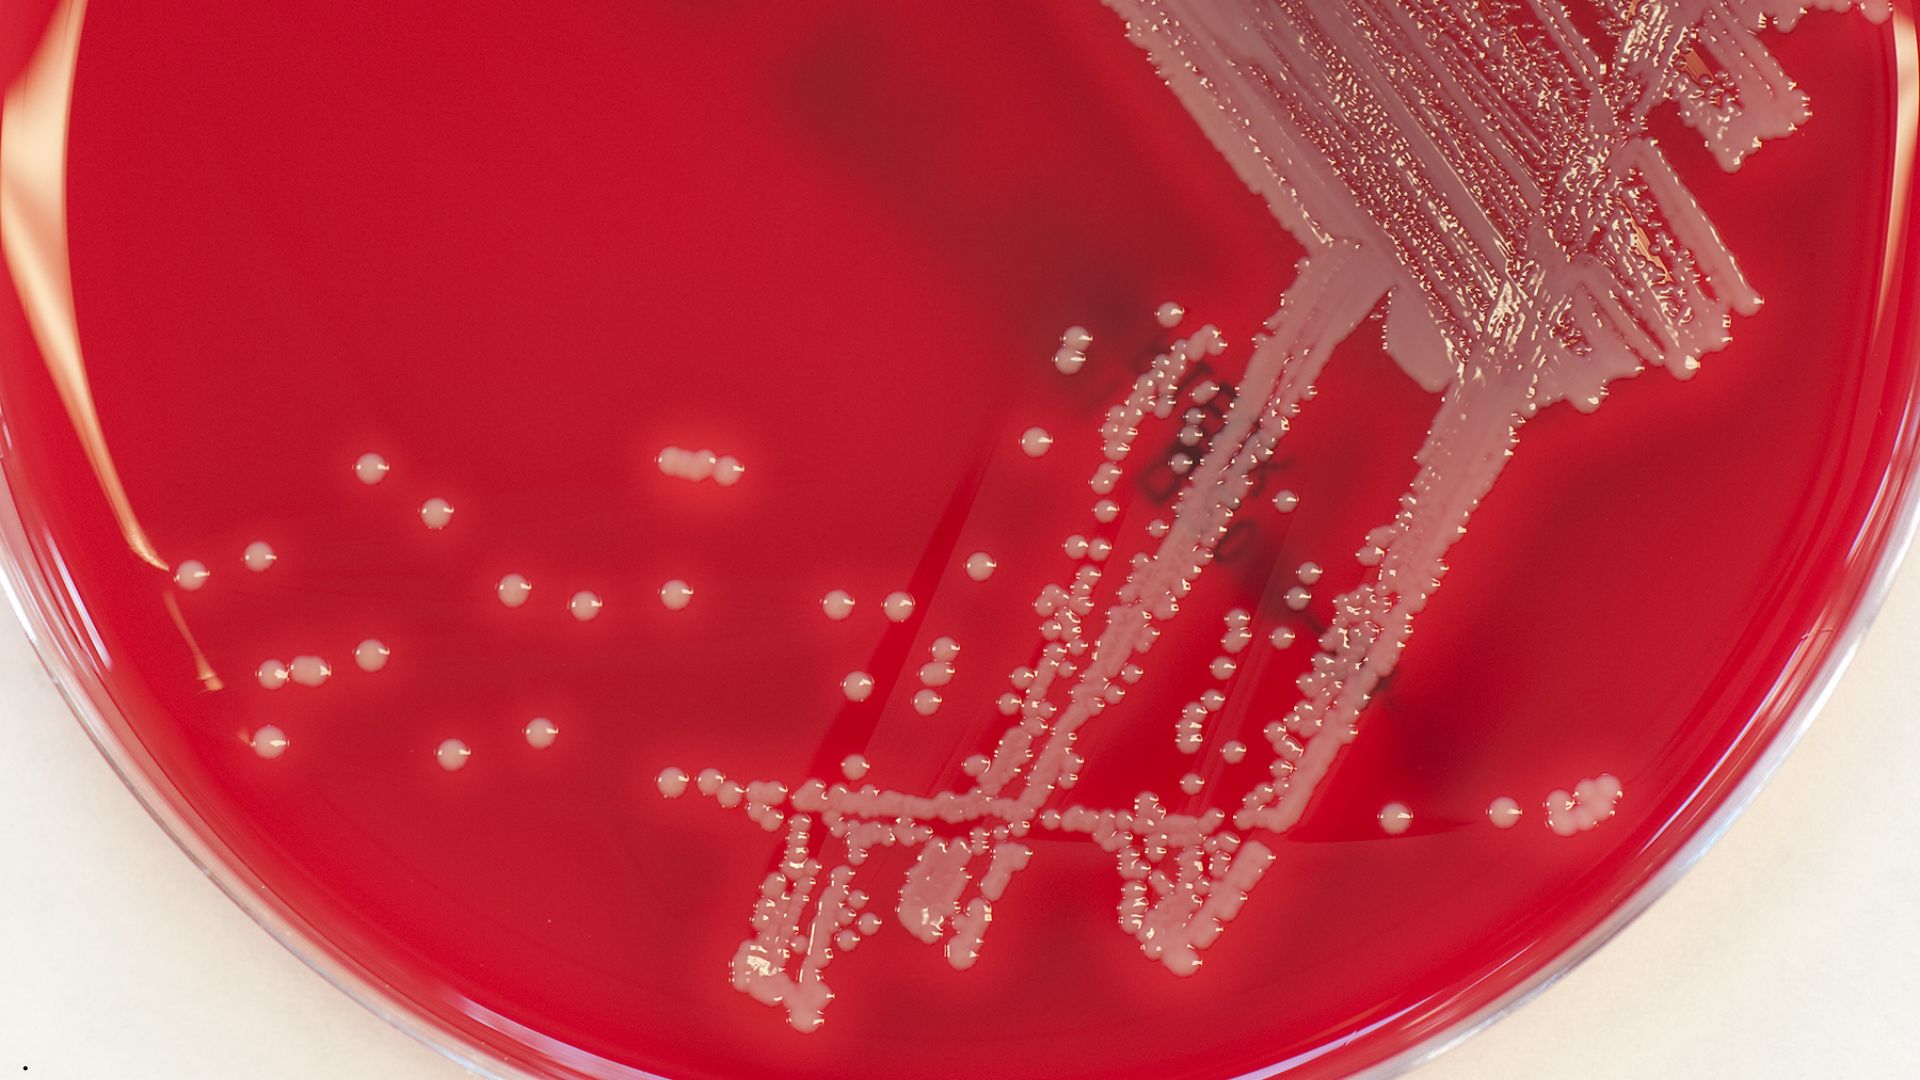

O S. aureus é o principal causador de mastite subclínica, aquela que não mostra sinais clínicos mas que deteriora silenciosamente a qualidade do leite
Vacas infectadas apresentam Contagem de Células Somáticas (CCS) elevada, o que compromete o pagamento por qualidade, reduz o rendimento de derivados como queijo e iogurte e o principal: reduz a capacidade produtiva da vaca.
Por que é tão difícil de controlar?
- Infecção invisível: na mastite subclínica, não há alterações visíveis no leite, ele tem aparência normal. O diagnóstico tardio é o primeiro grande obstáculo.
- Formação de biofilme: o S. aureus cria uma camada protetora no tecido mamário que bloqueia tanto o sistema imune da vaca quanto a ação dos antibióticos. Por isso, a taxa de cura bacteriológica em vacas em lactação é muito baixa.
- Resistência antimicrobiana: o uso indiscriminado de antibióticos ao longo de décadas gerou cepas cada vez mais resistentes. Tratar sem antibiograma é jogar no escuro.
- Transmissão durante a ordenha: o S. aureus é um patógeno contagioso, que passa de vaca para vaca pelas mãos do ordenhador, pelos equipamentos e pelos panos sem higienização adequada. Uma única vaca infectada e não identificada pode contaminar dezenas de outras ao longo da ordenha.
Como identificar o problema
Como a infecção não dá sinais visíveis, o diagnóstico depende de ferramentas específicas:
- CMT (California Mastitis Test): triagem rápida, fácil e de baixo custo por quarto mamário.
- CCS individual: vacas acima de 200.000 células/mL são consideradas vacas com mastite.
- Cultura microbiológica: diagnóstico definitivo, identifica o agente e ajuda a orientar o tratamento. Aliado à cultura microbiológica, o antibiograma ajuda a identificar quais medicamentos não fazem efeito na cepa e , portanto, não devem ser utilizados.
O que realmente funciona no controle
Não existe solução única. O controle eficaz exige uma abordagem integrada:
- Higiene rigorosa na ordenha: pré e pós-dipping, luvas, papel toalha descartavel ou toalhas individuais. Cada detalhe importa para conter a transmissão contagiosa.
- Terapia da vaca seca: a melhor janela terapêutica para o S. aureus. Antibióticos intramamários de longa ação aplicados na secagem têm taxas de cura superiores ao tratamento em lactação.
- Segregação de animais positivos: vacas diagnosticadas devem ser ordenhadas por último ou em equipamento acessório separado.
- Descarte estratégico: vacas com mastite crônica que falharam em múltiplos tratamentos raramente se curam e se tornam reservatórios permanentes. O descarte, analisado com objetividade, frequentemente é a melhor decisão econômica e sanitária.
- Manutenção do equipamento: teteiras desgastadas e vácuo desregulado causam lesões no canal do teto que facilitam a colonização. A manutenção preventiva é parte da estratégia sanitária.
O impacto econômico que muitos subestimam
O produtor não vê o leite sendo descartado, não trata emergencialmente, não observa a vaca doente — mas as perdas estão acontecendo: queda na produção, desconto por CCS elevada, menor rendimento industrial e descarte prematuro de animais geneticamente valiosos. A mastite subclínica é uma sangria silenciosa no resultado da propriedade.
Rebanhos com baixíssima prevalência de S. aureus existem e não são resultado de sorte. São resultado de protocolo, diagnóstico contínuo e decisões objetivas. A qualidade do leite começa na saúde do úbere, muito antes do tanque de expansão. O inimigo é silencioso. A resposta não pode ser.
![]()
Deseja receber e ler conteúdos exclusivos como esse em primeira mão?
Participe do nosso grupo de WhatsApp do Esteio Gestão.
Clique aqui e abra a porteira do conhecimento!
Ao clicar no link para ingressar em nosso grupo de WhatsApp, você está concordando em compartilhar seu contato para fins exclusivos de comunicação relacionada ao grupo, conforme autorizado pela Lei Geral de Proteção de Dados (Lei nº 13.709/2018). Seu número será tratado com segurança e privacidade, em total conformidade com a legislação.
Autor:

Eduarda Viana
Zootecnista
Ficou curioso e quer aprender mais sobre pecuária?
Leia mais em: https://esteiogestao.com.br/blog/
Use um sistema que te permite acessar as informações a qualquer momento e em qualquer lugar.
Você é produtor e quer gerenciar o seu negócio de forma prática e rápida? Conheça as nossas soluções agropecuárias em: https://esteiogestao.com.br/produtos-servicos
Nos acompanhe nas redes sociais e fique por dentro de todas as novidades.









